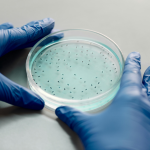
Microbiology

- Products
-
Reproduction
- Product overview - Reproduction
- Cancer Screening
- Vitrification
- Slow freezing
- Oocyte retrieval
- Sperm preparation
- Sperm diagnostics
- ICSI
- IVF
- Cultivation of embryos
- Embryo biopsy
- Embryotransfer and insemination
- Plastics
- EmbryoScope
- Laboratory instruments
- Endometrial tests
- Reproductive Genetics
- Sonohysterography
- Molecular diagnostics
-
Reproduction
- Careers
- About us
- Contacts